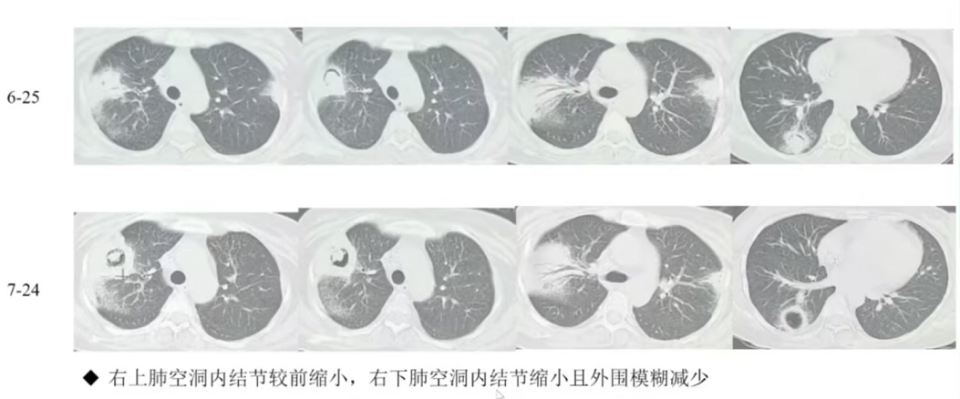

感染医线 发表时间:2026/2/14 17:17:32
编者按:2026年2月10日,《血液病/恶性肿瘤患者IFD的诊断标准与治疗原则(第七次修订版)》巡讲暨"血液新视野——IFD规范化诊疗学术交流会"召开。本次巡讲汇聚业内十余位大咖,围绕第七版指南展开系统解读与诊疗实例研讨,致力于推动指南加速落地临床,为广大医生提供更前沿的学术视角和更实用的临床指导。第七版指南立足最新循证证据完成多项重要更新,还结合临床痛点新增突破性IFD、毛霉病等诊疗方案,会议亦通过经典病例分享为实战诊疗提供参考。现将本次会议核心内容整理成文,为临床医师夯实IFD规范化诊疗能力、提升临床管理水平提供参考。
汇聚新证,策略升级--第七版指南更新要点解读
自2020年指南第6次修订以来,血液肿瘤治疗及IFD诊治领域均出现诸多新进展,对IFD流行病学及诊疗策略产生影响[1]。
流行病学方面,2021年更新的CAESAR 2.0研究[2]显示,我国异基因造血干细胞移植(allo-HSCT)后患者确诊/临床诊断IFD发生率为6.3%,非曲霉属丝状真菌的比例显著升高[1-3]。血液恶性疾病接受化疗的确诊/临床诊断IFD患者病死率约为16.7%,HSCT后IFD相关病死率可高达20.5%~72.6%,表明IFD仍是血液病/恶性肿瘤患者重要死亡原因之一[2-3]。

图1. 第七版指南更新流行病学数据[2-3]
诊断方面,第七版指南对IFD诊断方法进行更新。新增高分辨率计算机断层扫描血管造影(CTPA)、氟代脱氧葡萄糖正电子发射计算机断层显像(FDG-PET/CT)、宏基因组高通量测序技术(mNGS)等内容,并对半乳甘露聚糖试验(GM试验)、(1,3)‑β‑D‑葡聚糖试验(G试验)、多聚酶链式反应(PCR)等技术在IFD诊断中的应用进行更新[1]。
治疗方面,指南根据最新循证医学证据,优化了预防治疗、经验治疗及目标治疗的治疗方案,并新增突破性侵袭性真菌病(br-IFD)的管理,以及针对毛霉、肺孢子菌肺炎(PCP)和隐球菌病的目标治疗方案。指南建议 br-IFD的管理应综合多因素考量,实施个体化治疗[1]。

图2. 第七版指南新增突破性IFD的管理[1]
经验治疗选择覆盖曲霉、念珠菌的广谱抗真菌药物,首选卡泊芬净和两性霉素B脂质体(L-AmB)。目标治疗则应依据病原真菌进行选择。此外,指南进一步完善抗真菌治疗药物监测(TDM)依据及推荐意见,包括对于伏立康唑推荐常规开展TDM、两性霉素B类药物不推荐开展TDM等[1]。
聚焦挑战,攻坚克难--预防后突破性IFD的临床诊疗
突破性IFD的管理是第七版指南的新增内容[1]。突破性IFD是威胁血液病/恶性肿瘤患者预后及生存的重要原因,免疫抑制、真菌耐药、抗真菌谱未覆盖所有可能致病菌、药物组织浓度不足等因素均可能导致突破性IFD[4-5]。近年来,随着唑类药物预防的广泛应用,突破性霉菌感染占比较高,且耐药问题日益凸显[4,7],进一步增加突破性IFD的发生风险及管理难度。
由于接受抗真菌预防治疗,突破性IFD的临床症状减少并缺乏特异性,且病原学检测敏感度可能降低,从而导致延迟诊断[8-9]。因此,对于怀疑发生突破性IFD的患者,一方面需联合多种诊断方法和生物标志物,提高诊断率[4-5],另一方面需及早选择广谱、强效的抗真菌治疗药物,开展经验治疗或诊断驱动治疗[10]。

图3. 预防后突破性IFD的治疗[1,10]
多项研究表明,L-AmB用于IFD经验治疗具有良好的疗效[11-13]。对于伏立康唑预防后粒缺伴发热患者的经验治疗,L-AmB中位退热时间为4天,治疗成功率达89.5%[14]。此外,L-AmB与其他药物相互作用少见[15-17],标准剂量起始[18],且无需常规进行TDM[1]。广谱、强效、安全、简便的特点使L-AmB在临床应用中具备一定优势,使患者疑似发生突破性IFD时能够尽早接受有效的抗真菌治疗。

图4. L-AmB治疗伏立康唑预防后粒缺伴发热患者治疗成功率高[14]
“曲”径藏险,破局有道--侵袭性曲霉病的诊断与治疗
曲霉是血液病/恶性肿瘤患者IFD的常见病原真菌[2-3]。然而,由于对危险因素认知不充分[19]、多因素影响诊断准确性[20-21]、漏诊及延迟诊断导致管理不当[22-23]等问题,侵袭性曲霉病(IA)的管理仍面临巨大挑战。
普遍存在粒缺状态的血液病患者是发生IA的高危人群,临床可主要通过GM试验、胸部CT及气管镜检查等手段进行诊断[1,24],并善用PCR、NGS等技术[1],以降低漏诊率或诊断延迟。同时,对疑似IA的患者,可启动经验治疗或诊断驱动治疗[1]。
对于IA的目标治疗,第七版指南推荐常规采用抗真菌药物单药治疗。L-AmB是临床诊断和确诊IA患者治疗一线推荐药物之一。疗程推荐至少6~12周,根据IA临床严重程度、相关症状和体征恢复速度以及免疫抑制状态改善决定[1]。同时,《两性霉素B不同剂型临床合理应用多学科专家共识(2024版)》也指出:唑类或棘白菌素类药物预防期间出现突破性IA、既往发生过唑类耐药曲霉感染或定植、存在与唑类药物相关的严重药物间相互作用、肝功能不全、患者年龄<2岁、中枢神经系统IA等情况,推荐初始治疗优先选择L‑AmB[25]。

图5. 推荐IA初始治疗优选选择L-AmB的人群[25]
新章领航,驱“霉”除险--血液毛霉病的诊治
近年来,毛霉病的发生率持续升高,已成为我国allo-HSCT受者IFD的第二大病原真菌[2],且病死率高[26]。《中国毛霉病临床诊疗专家共识(2022)》指出,血液系统恶性肿瘤或HSCT、糖皮质激素和/或免疫抑制剂治疗、控制不良的糖尿病等均为毛霉感染的风险因素[27]。2022年,毛霉目真菌已被世界卫生组织真菌病原体清单(WHO FPPL)列为高度优先级病原体,亟需临床重视[28]。然而,由于当前影像学、组织病理学、微生物学检查存在特异性差、敏感度低、结果延迟等问题,易导致治疗延迟及患者预后不良[27,29-31]。因此,临床早期诊断、早期经验治疗对于改善患者预后至关重要。

图6. 第七版指南新增毛霉病的目标治疗[1]
根据第七版指南,L-AmB为毛霉病目标治疗首选药物 [1]。同时,《两性霉素B不同剂型临床合理应用多学科专家共识(2024版)》指出,在使用AmB类药物治疗毛霉病时,应在开始治疗的第1天即使用指南推荐的治疗剂量,不建议采用剂量递增方案,疗程建议为3~6周[25]。研究表明,L-AmB治疗毛霉病的缓解率高[32]、死亡率低[33],且安全性良好,可较ABLC及AmB-D降低患者肾毒性以及发热、寒战等输液相关反应发生率[34-35]。L-AmB因其疗效及安全性同样获得国外指南认可,被一致推荐用于毛霉病的一线治疗[36-37]。

图7. 国外指南推荐L-AmB用于毛霉病的一线治疗[36]
取之临床,用之临床--血液病患者IFD诊疗案例分享与讨论
会上针对一例复发/难治性急性髓系白血病(R/R AML)合并曲霉感染进行二次移植的病例进行分享与讨论。
患者因 AML接受allo-HSCT后全面复发且化疗效果不佳,遂入院接受MLL重排靶向药治疗,于骨髓抑制期间发生反复咳嗽及高热。经检查,胸部CT示肺部感染;外周血GM试验(+);肺泡灌洗液:GM试验(+),病原体NGS:洋葱伯克霍尔德杆菌序列数2,巨细胞病毒序列数45,人疱疹病毒6B序列数2,EB病毒序列数2;外周血NGS:黄曲霉序列数12881,烟曲霉序列数2279。

图8. 患者发生黄曲霉及烟曲霉感染
暂停靶向治疗,先后予以卡泊芬净、伏立康唑、艾沙康唑、L-AmB进行抗真菌治疗+间断中性粒细胞输注+广谱抗细菌、抗病毒治疗,患者仍持续发热且肺部感染持续进展。调整抗真菌治疗方案为L-AmB+艾沙康唑,适当增加L-AmB输注剂量,联合间断中性粒细胞输注,并恢复靶向治疗控制本病。经调整治疗方案,治疗后患者体温逐渐恢复正常。维持高剂量L-AmB联合艾沙康唑抗真菌治疗,期间患者耐受良好,未发生明显不良反应。复查胸部CT,部分感染灶稍吸收,部分较前相仿,真菌感染得到控制,为二次移植争取到宝贵的窗口期。患者整体状态稳定后行二次移植,+14天MLL-AF10基因转阴,+16天粒系重建,多次复查胸部CT示肺部感染病灶较前好转。至今维持L-AmB+艾沙康唑抗真菌治疗,同步予以抗细菌、抗病毒治疗。

图9. 患者经L-AmB+艾沙康唑治疗后转归情况
本病例资料中,患者因接受靶向治疗导致骨髓抑制,免疫功能低下,是IFD的高危人群。期间患者发生反复持续发热及肺部感染,通过NGS迅速明确黄曲霉及烟曲霉感染,先后予伏立康唑、艾沙康唑等药物治疗效果不理想,怀疑唑类耐药曲霉感染。临床第一时间换用L-AmB治疗,并根据患者临床特征调整剂量。考虑本例患者存在其他部位感染并可能为耐药曲霉感染,因此联合艾沙康唑治疗。在强效的抗曲霉治疗下成功控制曲霉感染。同时,L-AmB治疗期间,患者耐受良好,未发生明显不良反应。患者最终获得较为理想的抗真菌治疗疗效,并顺利进行二次移植。
总结
2025年,《血液病/恶性肿瘤患者IFD的诊断标准与治疗原则(第七次修订版)》正式发布,基于近年来血液肿瘤治疗及IFD诊治领域的新进展进行了流行病学及诊疗策略的重要更新,对提升我国血液病/恶性肿瘤患者IFD的规范化诊疗水平具有重要意义。在不久的未来,相信随着指南逐步落地实施,我国IFD管理水平将迈上新高度,为广大患者带来更大程度获益。
参考文献
[1] 中国医师协会血液科医师分会,等. 中华内科杂志,2025,64(12):1155-1168.
[2] Li C, et al. Clin Infect Dis. 2025 Apr 30;80(4):807-816.
[3] Sun Y,et al. Biol Blood Marrow Transplant. 2015 Jun;21(6):1117-26.
[4] Jenks JD,et al.Mycoses . 2020 Oct;63(10):1021-1032.
[5] Girmenia C, et al.Med Mycol. 2019 Apr 1;57(Supplement_2):S127-S137.
[6] Fisher BT,et al.JAMA. 2019 Nov 5;322(17)1673-1681.
[7] Verweij PE et al. Drug Resist Updat. 2009 Dec;12(6):141-7.
[8] Peterson L, et al.Mycoses . 2013 Nov;56(6):651-8.
[9] Calmettes C, et al.Oncotarget. 2018 Jun 1;9(42):26724-26736
[10] 朱丹苹,等. 中华医学杂志,2024,104(37):3543-3548.
[11] Walsh TJ, et al. N Engl J Med. 2002 Jan 24;346(4):225-34.
[12] De la Serna J, et al. Rev Esp Quimioter. 2013 Mar;26(1):64-9.
[13] Yoshida M, et al. J Infect Chemother. 2021 Feb;27(2):277-283.
[14] Kobayashi R,et al.Pediatr Int . 2021 May;63(5):550-555.
[15] Nivoix Y et al. Semin Respir Crit Care Med . 2020 Feb;41(1):158-174.
[16] Megías-Vericat JE, et al.Ann Hematol.2020 Sep;99(9):1989-2007
[17] Chelsea Gustafson,et al. Current Fungal Infection Reports.2020;14:130–140.
[18] 安必速®(注射用两性霉素B脂质体)说明书
[19] 中华医学会呼吸病学分会. 中华结核和呼吸杂志,2025,48(12):1104-1126.
[20] Rosam K, et al. Expert Rev Mol Diagn. 2025 Jul;25(7):313-327.
[21] Lass-Flörl C. Clin Microbiol Infect. 2025 Dec;31(12):1980-1984.
[22] L. Maessen, et al. ESCMID 2025 Poster E0598
[23] 吴凡,等. 中国小儿急救医学,2022,29(7):525-529.
[24] 施毅.中国临床研究,2023,36(4):481-486.
[25] 中国医药教育协会真菌病专业委员会.中华内科杂志.2024,63(3):230-257.
[26] Denning DW. Lancet Infect Dis. 2024 Jan 12:S1473-3099(23)00692-8.
[27] 中国医药教育协会真菌病专业委员会,等.中华内科杂志,2023,62(6):597-605.
[28] WHO fungal priority pathogens list to guide research, development and public health action
[29] Dailey Garnes NJM, et al. Curr Opin Infect Dis. 2023 Dec 1;36(6):427-435.
[30] Ponnaiyan D,et al. Exp Ther Med. 2022 Dec 5;25(1):47.
[31] Sharma A, et al. Infect Disord Drug Targets. 2024;24(1):e220823220209.
[32] French Mycosis Study Group. J Antimicrob Chemother. 2015 Nov;70(11):3116-23.
[33] Skiada A, et al. Clin Microbiol Infect. 2011 Dec;17(12):1859-67.
[34] Walsh TJ, et al. N Engl J Med. 1999 Mar 11;340(10):764-71.
[35] Wingard JR, et al. Clin Infect Dis. 2000 Nov;31(5):1155-63.
[36] Cornely OA, et Al. Lancet Infect Dis. 2019 Dec;19(12):e405-e421.
[37] Tissot F, et al. Haematologica. 2017 Mar;102(3):433-444.
来源:《感染医线》
声 明
凡署名原创的文章版权属《感染医线》所有,欢迎分享、转载(开白可后台留言)。本文仅供医疗卫生专业人士了解最新医药资讯参考使用,不代表本平台观点。该等信息不能以任何方式取代专业的医疗指导,也不应被视为诊疗建议,如果该信息被用于资讯以外的目的,本站及作者不承担相关责任。
